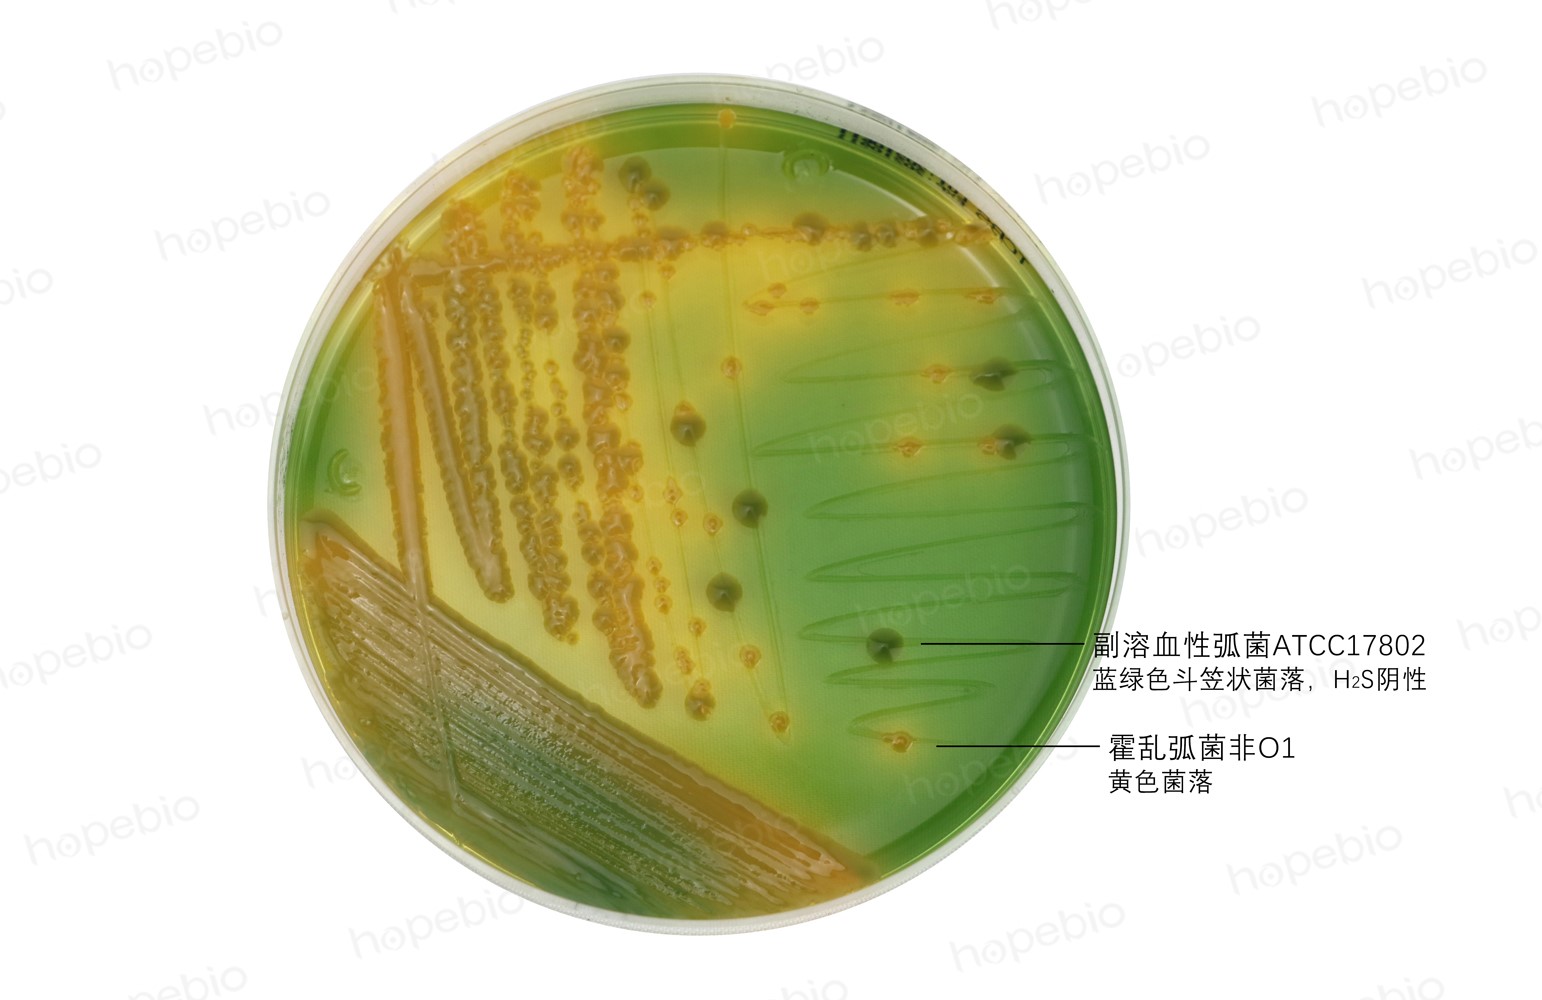

海博微信公众号
海博微信公众号
 海博天猫旗舰店
海博天猫旗舰店


 海博微信公众号
海博微信公众号
 海博天猫旗舰店
海博天猫旗舰店




在微生物世界中,许多微生物具备自主运动的能力,这种动力特性不仅是它们适应环境、获取营养的重要手段,也为微生物分类鉴定、疾病诊断等领域提供了关键依据。
一、常见的有动力细菌
微生物的动力主要依赖于其特殊的运动结构,如鞭毛、纤毛等,其中细菌是动力特征最为丰富的微生物类群,绝大多数有动力细菌依靠鞭毛实现运动。根据鞭毛着生位置的不同,可分为周毛菌、端毛菌、丛毛菌等,不同类型细菌的运动能力和方式各有特点。
1、大肠埃希氏菌
大肠埃希氏菌是典型的周毛菌,其细胞表面均匀分布着数十根鞭毛,能在液体环境中实现灵活的直线运动和转向运动。大肠埃希氏菌的动力特性与其在自然环境中的生存密切相关,例如在人体肠道内,它可通过运动穿越黏液层,到达肠道黏膜表面获取营养物质。在实验室培养中,具有动力的大肠埃希氏菌在半固体培养基中会呈现出典型的扩散生长特征,这也是区分有动力菌株和无动力突变株的重要依据。此外,大肠埃希氏菌的动力还与其致病性存在关联,某些致病性菌株的鞭毛不仅是运动器官,还能作为毒力因子,帮助细菌黏附宿主细胞,增强感染能力。
2、霍乱弧菌
霍乱弧菌属于端毛菌,其细胞一端着生一根粗壮的单鞭毛,运动能力极强,在显微镜下观察时可呈现出快速的“穿梭样”运动。这种强大的动力使霍乱弧菌能在水体环境中快速扩散,尤其是在污染的水源中,可通过运动主动接近宿主肠道。霍乱弧菌的鞭毛蛋白还具有免疫原性,是疫苗研发的重要靶点之一,其动力特性也成为临床诊断中鉴别该菌的重要指标。在暗视野显微镜下,霍乱弧菌的快速运动特征可与其他肠道细菌明显区分。
3、铜绿假单胞菌
铜绿假单胞菌是典型的丛毛菌,细胞一端着生多根鞭毛,运动方式以直线运动为主,且运动速度较快。该菌广泛存在于土壤、水体等自然环境中,其动力特性使其能快速适应不同的生存环境,例如在医院环境中,可通过运动扩散至医疗器械表面,引发交叉感染。铜绿假单胞菌的动力还与其生物被膜的形成有关,具有动力的菌株能更高效地附着在生物材料表面,形成难以清除的生物被膜,导致慢性感染。在临床检测中,通过观察其动力特征,可辅助判断该菌是否为致病性菌株。
4、伤寒沙门菌
伤寒沙门菌同样属于周毛菌,细胞周身布满鞭毛,运动方式灵活,能在液体培养基中形成均匀的浑浊液。伤寒沙门菌的动力特性与其在宿主体内的传播密切相关,它可通过运动穿透人体肠道上皮细胞,进入淋巴系统和血液循环,引发伤寒病。在实验室检测中,半固体培养基穿刺培养法是鉴别伤寒沙门菌的重要手段之一。培养后该菌会沿穿刺线向周围扩散生长,使培养基整体浑浊,而无动力的肠道细菌则仅在穿刺线处生长。此外,伤寒沙门菌的鞭毛抗原(H抗原)是血清学诊断的关键指标,其动力特性与抗原性紧密相关
5、变形杆菌
变形杆菌包括普通变形杆菌、奇异变形杆菌等,属于周毛菌,具有极强的运动能力,其运动方式以“迁徙生长”为典型特征。在固体培养基上,变形杆菌的菌落会从接种点向四周快速扩散,形成一层薄薄的、边缘不整齐的生长区域,宛如“薄膜”覆盖在培养基表面,这种生长特征与其强大的动力密切相关。变形杆菌广泛存在于土壤、粪便等环境中,部分菌株可引起人体泌尿系统感染、伤口感染等疾病。其动力特性不仅是分类鉴定的重要依据,还与其耐药性的传播有关,具有动力的菌株能更快速地与其他细菌接触,通过接合转移等方式获取耐药基因。
6、副溶血性弧菌
副溶血性弧菌是端毛菌,细胞一端着生一根鞭毛,运动能力较强,在含盐环境中(如海水、海产品)运动更为活跃。该菌是引起食物中毒的常见病原菌,主要通过污染的海产品(如虾、蟹、贝类)进入人体。副溶血性弧菌的动力特性使其能在海产品体内快速扩散,同时在实验室培养中,通过半固体培养基(含3%-3.5%氯化钠)穿刺培养,可观察到其沿穿刺线扩散生长的特征,这也是区分该菌与其他非动力弧菌的重要依据。
二、微生物动力的检测方法
微生物动力的检测是微生物学研究和临床诊断中的重要环节,基于培养基的检测方法凭借操作简便、成本较低、结果直观等优势,成为实验室中最常用的动力检测手段。
1、半固体培养基
半固体培养基是检测微生物动力的核心培养基类型,其琼脂含量较低(通常为0.3%-0.5%),质地柔软,既能为微生物生长提供营养,又能让有动力的微生物自由运动,通过观察微生物在培养基中的生长形态即可判断其动力。
(1)普通营养半固体培养基穿刺培养法
检测细菌动力的经典方法,适用于大多数需氧和兼性厌氧细菌的动力检测。有动力的细菌沿穿刺线向周围扩散生长,使整个培养基呈现均匀浑浊状态,部分细菌还会在培养基表面形成一层菌膜。例如大肠埃希氏菌、伤寒沙门菌培养后均会出现这种特征。无动力的细菌仅在穿刺线处生长,形成一条清晰的“线状”菌落,培养基其余部分保持澄清透明。例如肺炎链球菌、痢疾志贺菌等无动力细菌的培养结果。
优点是结果直观、准确性高,适用于大多数常见细菌的动力检测;缺点是检测周期受细菌生长速度影响,厌氧菌培养时间较长。

图1 不同细菌在半固体琼脂上的生化反应现象
(2)选择性半固体培养基穿刺培养法
针对某些特殊细菌(如弧菌、厌氧菌),普通营养半固体培养基无法满足其生长需求,需使用添加特定成分的选择性半固体培养基,既能筛选目标细菌,又能检测其动力。
以弧菌选择性半固体培养基为例(用于检测霍乱弧菌、副溶血性弧菌等),有动力的弧菌沿穿刺线快速扩散生长,培养基整体浑浊,且在培养基表面可能形成薄而透明的菌膜(如霍乱弧菌)。无动力的菌仅穿刺线处有菌落生长,培养基澄清。
优点是可同时实现弧菌的筛选和动力检测,减少杂菌干扰,适用于临床标本(如粪便、水样)中弧菌的动力鉴定;缺点是培养基成分相对复杂,制备成本略高。

图2 弧菌在3%氯化钠V-P半固体生化管上的生化反应现象
2、固体培养基检测法
固体培养基的琼脂含量较高(通常为1.5%-2%),质地较硬,有动力的微生物可在培养基表面或浅层扩散生长,通过观察菌落形态和扩散范围判断动力,主要包括平板划线扩散法和迁徙生长观察法。
(1)平板划线扩散法
适用于运动能力较强的细菌(如变形杆菌、霍乱弧菌),通过划线接种后观察细菌是否从划线区域向周围扩散生长。
普通营养琼脂平板(适用于大多数细菌)、TCBS琼脂平板(适用于弧菌)。有动力的细菌从划线区域向周围扩散生长,形成边缘不整齐、呈云雾状或绒毛状的生长区域,严重时可覆盖整个平板表面(如变形杆菌);霍乱弧菌在TCBS琼脂平板上划线后,菌落会沿划线方向扩散,形成“拖尾”状菌落。无动力的细菌仅在划线轨迹上生长,形成孤立、边缘整齐的圆形或椭圆形菌落(如大肠埃希氏菌在普通琼脂平板上的无动力突变株)。
优点是操作简便,可快速初步判断细菌动力,且能同时观察菌落形态;缺点是受培养基湿度、培养时间影响较大,湿度较高时易出现假阳性(非动力细菌因培养基湿润导致菌落扩散),湿度较低时可能出现假阴性。
图3 霍乱弧菌在TCBS培养基上的生长现象
(2)迁徙生长观察法
专门用于检测变形杆菌的动力,变形杆菌具有极强的运动能力,在固体培养基上会呈现独特的“迁徙生长”特征。
普通营养琼脂平板(可添加0.1%葡萄糖,促进变形杆菌生长)。有动力(典型迁徙生长)的细菌从接种点向四周快速扩散,形成一层薄薄的、边缘不整齐的“薄膜状”生长物,扩散区域内可见细小的菌落,随着培养时间延长,可逐渐覆盖整个平板表面,培养基颜色可能因细菌代谢产物而发生变化(如普通变形杆菌可使培养基呈现褐色)。无动力的细菌如变形杆菌的无动力突变株,仅在接种点形成一个圆形、边缘整齐的菌落,无扩散现象。
优点是特异性强,是鉴别变形杆菌的重要依据;缺点是仅适用于变形杆菌,适用范围较窄。
3、液体培养基检测法
液体培养基不含琼脂,微生物可在其中自由生长和运动,有动力的微生物会使培养基呈现均匀浑浊,无动力的微生物则多在培养基底部生长,形成沉淀,主要包括静置培养观察法和摇瓶培养对比法。
(1)静置培养观察法
适用于大多数细菌的动力初步检测,通过观察细菌在液体培养基中的生长状态判断动力。
有动力的细菌在液体培养基中均匀生长,整个培养基呈现浑浊状态,部分细菌还会在培养基表面形成一层菌膜(如铜绿假单胞菌),底部仅少量沉淀。无动力的细菌主要在培养基底部生长,形成明显的沉淀,培养基上层保持澄清或轻微浑浊(如肺炎链球菌)。
优点是操作最简单,无需复杂的接种工具,可作为动力检测的初步筛选方法;缺点是结果准确性较低,部分运动能力较弱的细菌可能与无动力细菌表现相似,需结合其他方法进一步确认。

图4 细菌在TSB培养基中的生长现象
(2)摇瓶培养对比法
通过对比静置培养和摇瓶培养下细菌的生长状态,更准确地判断其动力,适用于运动能力较弱的细菌。
有动力的细菌A管(静置)中细菌均匀浑浊,B管(振荡)中细菌生长更旺盛,浑浊度更高(因振荡促进氧气供应,且细菌运动使营养物质更易接触)。无动力的细菌A管中细菌主要沉淀于底部,上层澄清;B管中因振荡作用,细菌分散,浑浊度略高于A管,但仍低于有动力细菌的B管。
优点是能更准确区分运动能力较弱的细菌与无动力细菌,减少误判;缺点是需要摇床设备,培养过程相对复杂。
三、相关产品
部分可检测细菌动力的培养基:
|
产品货号 |
产品名称 |
用途 |
|
GB008 |
用于动力观察,菌种保存,H抗原位相变异试验等 |
|
|
GB131 |
用于副弧的动力和V-P实验 |
|
|
HB4168 |
用于动力观察,菌种保存,H抗原位相变异试验 |
|
|
GB048 |
用于蜡样芽孢杆菌生化鉴定 |
|
|
HB0177 |
一种通用的营养培养基,用于各种微生物的培养 |
|
|
HB4130 |
用于致病性弧菌的选择性分离。 |
|
|
HB4114 |
一种通用的微生物营养增菌肉汤 |
注:本文属海博生物原创,未经允许不得转载。
下一篇:细胞培养基所需要的常规添加剂
| 相关文章: |



